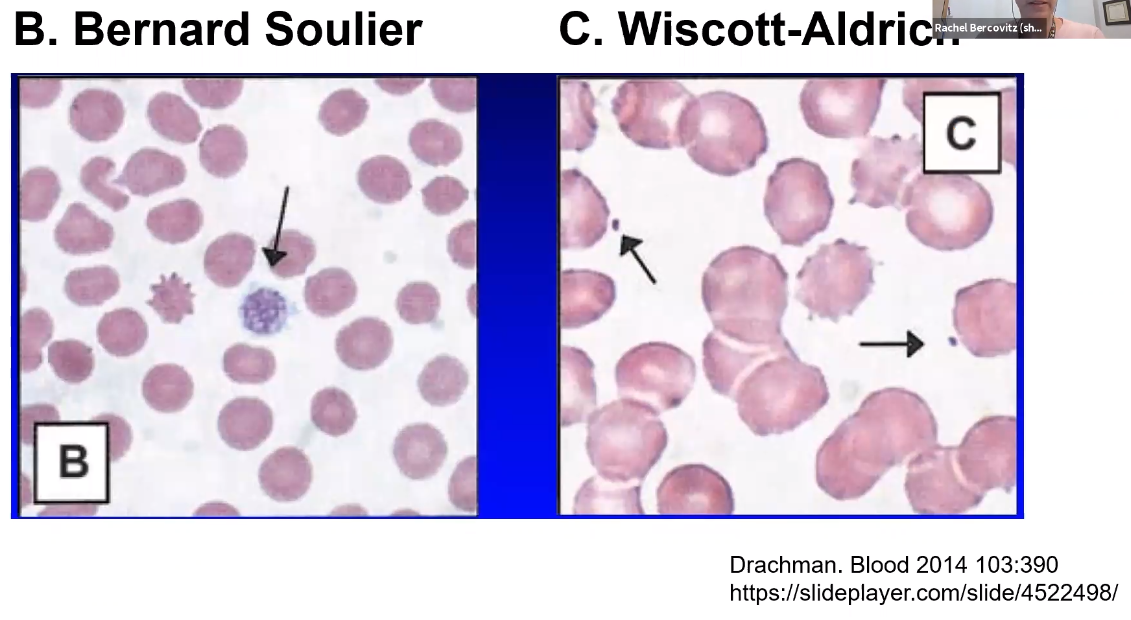

How can a patient with a factor deficiency have normal PT/PTT?
PT and PTT only become abnormal when coagulation factors drop below 30-40%
=> Mild deficiencies can have normal PT and PTT
Measure specific clotting factor deficiencies if clinical suspicion is high
Describe the amplification loop of the coagulation cascade
Initially, a small amount of thrombin is produced
Thrombin further activates V, VIII, XI
Results in lots of thrombin

What is the only thrombocytopenia that will have platelets that are too small?
Wiscott-Aldrich
Defect in WAS gene; responsible for stabilizing actin cytoskeleton
What clotting factor activates prothrombin -> thrombin?
Xa

Deficiency of which clotting factor will result in elevated PT with normal PTT?
F VII

What are the endogenous inhibitors of Factor Va and VIIIa? (2)
Activated protein C
with cofactor protein S

Which factor deficiency is most likely to present with bleeding a few days after surgery?
Factor XI deficiency
Hemophilia C
What are the treatments for hemophilia C?
Fresh frozen plasma
Anti-fibrinolytic agents
What is the most likely diagnosis in an adult patient, on no relevant medications, who has:
Immune thrombocytopenia purpura: type of thrombocytopenia involving the formation of autoantibodies against platelets.
List 2 treatment options for immune thrombocytopenia purpura (ITP)
According to boards…
In real life, usually observe unless pt is bleeding or at high risk
Which clotting factor is deficient in:
What procoagulant factors are inhibited by tissue factor pathway inhibitor (TFPI)? (2)
Factor Xa
TF/Factor VIIa

What endogenous substance initiates breakdown of a fibrin clot?
What are the subsequent steps?
tPA initiates
Activates plasminogen -> plasmin
Plasmin breaks down the fibrin clot
Results in D-dimer formation

List the 2 major mechanisms of platelet destruction pathologies:
What is the mechanism and outcome of:
What is the treatment for vWF disease?
Desmopressin
vWF concentrate
What duration defines each of the following thrombocytopenias?
Each time interval indicates time that platelet count has been low
Which laboratory test is abnormal in a patient with severe hemophilia A?
PTT
When is immune thrombocytopenia purpura treated?
Significant bleeding
High risk for traumatic bleeding
(toddlers, sports, phsysical demand)
Caused by antibodies against GpIIb/IIIa
Describe the pathophysiology of heparin-induced thrombocytopenia (HIT)
Tx: Remove heparin, give direct thrombin inhibitor
What are the endogenous inhibitors of thrombin? (2)
Antithrombin
Thrombomodulin

What are the two most commonly mutated proteins in hereditary hemorrhagic telangiectasia?
Endoglin or ALK-1 gene
HHT: hereditary, systemic vasculopathy characterized by telangiectasia on the skin and mucosa, particularly in the area of the face (nose, lips, tongue)
Which clotting factor cross-links fibrin
Factor XIII (Fibrin stabilizing factor)
What is the most likely cause of prolonged PT or PTT that does NOT correct with a mixing study?
Inhibitor
Specific factor inhibitor or lupus anticoagulant
